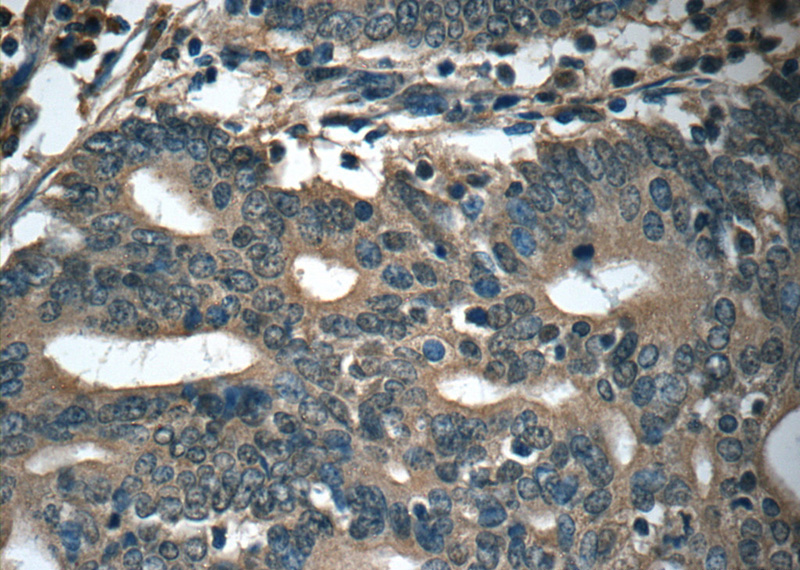
Immunohistochemistry of paraffin-embedded human endometrial cancer tissue slide using Catalog No:111665(IFT20 Antibody) at dilution of 1:50 (under 40x lens)

-
Product Name
IFT20 antibody
- Documents
-
Description
IFT20 Rabbit Polyclonal antibody. Positive IHC detected in human endometrial cancer tissue. Positive IF detected in hTERT-RPE1 cells, MDCK cells. Positive IP detected in mouse testis tissue. Positive WB detected in mouse pancreas tissue, HEK-293 cells, mouse kidney tissue, mouse lung tissue. Observed molecular weight by Western-blot: 15-18 kDa
-
Tested applications
ELISA, IF, WB, IP, IHC
-
Species reactivity
Human, Mouse; other species not tested.
-
Alternative names
hIFT20 antibody; IFT20 antibody
-
Isotype
Rabbit IgG
-
Preparation
This antibody was obtained by immunization of IFT20 recombinant protein (Accession Number: NM_001267775). Purification method: Antigen affinity purified.
-
Clonality
Polyclonal
-
Formulation
PBS with 0.02% sodium azide and 50% glycerol pH 7.3.
-
Storage instructions
Store at -20℃. DO NOT ALIQUOT
-
Applications
Recommended Dilution:
WB: 1:200-1:1000
IP: 1:200-1:2000
IHC: 1:20-1:200
IF: 1:20-1:200
-
Validations

mouse pancreas tissue were subjected to SDS PAGE followed by western blot with Catalog No:111665(IFT20 antibody) at dilution of 1:400

IF result (localization to Golgi-like structures) of anti-IFT20 (Catalog No:111665, 1:50) with serum-starved hTERT-RPE1 (MoTH fixed) by Dr. Moshe Kim.

IP Result of anti-IFT20 (IP:Catalog No:111665, 3ug; Detection:Catalog No:111665 1:700) with mouse testis tissue lysate 4000ug.

Immunohistochemistry of paraffin-embedded human endometrial cancer tissue slide using Catalog No:111665(IFT20 Antibody) at dilution of 1:50 (under 10x lens)
Immunohistochemistry of paraffin-embedded human endometrial cancer tissue slide using Catalog No:111665(IFT20 Antibody) at dilution of 1:50 (under 40x lens)
-
Background
Intraflagellar transport (IFT), mediated by molecular motors and IFT particles, is an important transport process that occurs in the cilium. IFT particles are multi-subunit complexes that are made up of complex A and complex B. IFT20 is a component of IFT complex B and involved in ciliary process assembly. It is associated with the Golgi complex and plays a role in the trafficking of ciliary membrane proteins from the Golgi complex to the cilium.
-
References
- Inoko A, Matsuyama M, Goto H. Trichoplein and Aurora A block aberrant primary cilia assembly in proliferating cells. The Journal of cell biology. 197(3):391-405. 2012.
- Vivar OI, Masi G, Carpier JM. IFT20 controls LAT recruitment to the immune synapse and T-cell activation in vivo. Proceedings of the National Academy of Sciences of the United States of America. 113(2):386-91. 2016.
- Inaba H, Goto H, Kasahara K. Ndel1 suppresses ciliogenesis in proliferating cells by regulating the trichoplein-Aurora A pathway. The Journal of cell biology. 212(4):409-23. 2016.
- Hurd T, Zhou W, Jenkins P. The retinitis pigmentosa protein RP2 interacts with polycystin 2 and regulates cilia-mediated vertebrate development. Human molecular genetics. 19(22):4330-44. 2010.
- Zhang Q, Seo S, Bugge K, Stone EM, Sheffield VC. BBS proteins interact genetically with the IFT pathway to influence SHH-related phenotypes. Human molecular genetics. 21(9):1945-53. 2012.
- Joo K, Kim CG, Lee MS. CCDC41 is required for ciliary vesicle docking to the mother centriole. Proceedings of the National Academy of Sciences of the United States of America. 110(15):5987-92. 2013.
- Pampliega O, Orhon I, Patel B. Functional interaction between autophagy and ciliogenesis. Nature. 502(7470):194-200. 2013.
- Greer YE, Westlake CJ, Gao B. Casein kinase 1δ functions at the centrosome and Golgi to promote ciliogenesis. Molecular biology of the cell. 25(10):1629-40. 2014.
Related Products / Services
Please note: All products are "FOR RESEARCH USE ONLY AND ARE NOT INTENDED FOR DIAGNOSTIC OR THERAPEUTIC USE"
